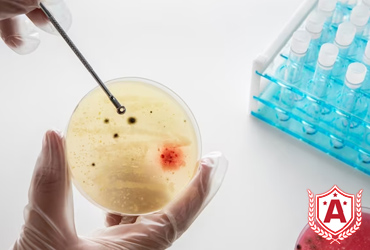
Study Integrated Immunology in Germany

Updated on Dec, 27 2025 05:03 IST
Integrated Immunology in Germany is a challenging course for students. Germany is an educational hub famous for its advanced curriculum and study resources. Students who want to study abroad should definitely keep Germany as their top choice. Germany is also very comfortable for living in terms of expenses and basic amenities. Germany is known for its research and advancements in science, especially biology. Integrated immunology studies different organisms' immune systems and DNA. The subject is a comprehensive and in-depth study of different genetics. Immunology is related to biology. It extends its branches into technology too. Students who study the subject in Germany will have a huge scope of job opportunities lined up for them. If you want to know more about bachelors in integrated immunology in Germany, then you have come to the right place. Read ahead to get to know more about different scholarships, universities and high-paying job opportunities.
Integrated Immunology in Germany is a challenging course for students. Germany is an educational hub famous for its advanced curriculum and study resources. Students who want to study abroad should definitely keep Germany as their top choice. Germany is also very comfortable for living in terms of expenses and basic amenities. Germany is known for its research and advancements in science, especially biology. Integrated immunology studies different organisms' immune systems and DNA. The subject is a comprehensive and in-depth study of different genetics. Immunology is related to biology. It extends its branches into technology too. Students who study the subject in Germany will have a huge scope of job opportunities lined up for them. If you want to know more about bachelors in integrated immunology in Germany, then you have come to the right place. Read ahead to get to know more about different scholarships, universities and high-paying job opportunities.
| Program | Study Integrated Immunology in Germany |
| Course Duration | 3 to 5 years |
| Language of Instruction | Primarily German for Bachelors, rarely English (for private institutions) |
| Tuition Fees | Free in Public Universities |
| Living Cost in Germany | 700-1000 EUR per month |
| Other Fees | Around 50,000 EUR per annum |
| Sessions | Summer and Winter |
If you are unsure about your bachelors in integrated immunology in Germany, take a quick look at the top 6 reasons to study in Germany:
Affordable living: Students do not need to spend more than 1000 EUR to live comfortably in Germany. Public facilities in the country are mostly free, or they charge very low cost making Germany a student-friendly place to live in.
No tuition fees: You can study free in Germany in public universities where you only need to pay an administrative fee. Public universities do not charge tuition fees. Private universities can charge up to 26,000 EUR yearly.
Accommodating Environment: Germany is a very welcoming place for international students. Around 37% of the student community is from overseas. Also, there are plenty of student-friendly places in Germany that one can visit.
Diversity: German universities’ students get exposure to different cultures and backgrounds from all over the world. Germany's residents also respect different communities from all over the world, making the country a happy place to live in.
Scholarships: If you want to study in Germany for free in bachelors in integrated immunology, you can easily apply for scholarships. Scholarships are provided by different private universities and foundations and the German government. .
Curriculum: Universities have very comprehensive syllabi for students to gain experience in real-life fields apart from textbooks. Students also get to take part in additional research.
If you have been contemplating doing a bachelor’s in Integrated Immunology in Germany, you need to make sure you are eligible for it. Here is a checklist.
Students should have completed their 10+2 in any stream.
Students should have a total of 13 years of educational experience. This should include 12 years of schooling and one year of preparation for your undergraduate program.
The minimum CGPA is 8.5. If you are aiming for top universities and scholarships, you need to have more than that.
The medium of instruction in German universities is German for their bachelor’s programs. In order to prove your proficiency, you need to have a B1 or C1 level certificate.
It is necessary to present English and German language proficiency certificates such as TOEFL (90-100 score) or IELTS (6.5.-7 band score) and B2 or C1 level certification to be eligible for pursuing this program.
It is mandatory to have a letter of recommendation for securing admission to German universities.
A Statement of Purpose also needs to be presented for becoming eligible for a bachelor's in integrated immunology.
The medium of instruction in German universities for bachelor’s programs is German and English. You need to have a B1 or C1 level certificate for selecting German as your course language.
English is also an instruction language for pursuing a bachelor's in integrated immunology. Depending on the university, you will have to present either of the following certificates -
TOEFL - a score of 90-100
IELTS - a score of 6.5+ bands
As an applicant, you need to know about the last date of application submission. The application deadline depends on which session you are applying to - the winter session or the summer intake. In the case of the winter session, the deadline is somewhere in July. Whereas in the case of summer intake, the deadline for application submission is in January. Most international students prefer the winter session; however, both intakes have the same value in front of the educational board.
Here is a list of documents that you need to have with you when you proceed with your admission -
12th mark sheets
Your certificate of enrollment
CV and experience letter, if required
Application Copy
Statement of Purpose(SOP) written by you
Certificate of proficiency in German (B2 or C1) to prove your language proficiency
English language Proficiency certificate, depending on the university with the mentioned cut-off
Receipt of fee payment should be produced in the case of private universities.
Passport
Financial Records statement
Medical Certificate
Letter of Recommendation(LOR) from your school professors
There is no tuition fee in German public universities; however, they do take semester fees that cover administrative charges. This semester fees range from EUR 100 to EUR 500. In private universities, the fees can be as much as EUR 40,000 to EUR 50,000.
Here are some universities that are good for a bachelor’s in integrated immunology -
The University of Rostock: There is no tuition fees
Karlsruhe Institute of Technology: EUR 1500 per semester.
The Technical University of Munich: EUR 300 per semester and per week.
The University of Saarland includes EUR 289 per month.
University of Freiburg: 150 EUR per semester
The Free University of Berlin does not charge any tuition fees from students.
Here are some notable scholarships that students can avail of in order to make their undergraduate education experience seamless and less burdensome -
DAAD Scholarship Germany: Provides full coverage of tuition fees and travel allowance.
Erasmus Scholarship Programs in Germany: This scholarship covers all the tuition fees, monthly allowances, and travel charges.
Heinrich Boll Scholarships for International Students: It waived EUR 1450 Per Month to the students.
Konrad-Adenauer-Stiftung (KAS) Scholarships: It waived EUR 850 every month for students.
The Friedrich Ebert Stiftung: Provides full coverage of tuition fees and travel allowance.
There are many universities you can opt for to take admission in bachelors in integrated immunology in Germany. Here is a list of some of the most popular universities:
The University of Rostock.
Karlsruhe Institute of Technology.
The Technical University of Munich.
The Ludwig Maximilian University of Munich.
University of Saarland.
University of Freiburg.
The Free University of Berlin.
The admission procedure for undergraduate programs can be a tough thing to tackle when you look at it. However, if you break down the procedure into steps, you can have an easy way with it.
Contact our team at Anigdha. We will guide you and help you create a shortlist of universities you should apply to.
Our team can help you fill out the application and update the required details.
Once you are done with your application, we will go over it to make sure there are no errors, and you can then submit it.
You need to pay application fees, and after that, you will get confirmation from the desired university.
Anigha will be there with you at every step, including acquiring a student visa, passport, accommodation in Germany, flight tickets, etc.
Is bachelors in integrated immunology in Germany challenging?
Yes, it is a difficult course to study. The subject is not for everyone, but if students understand and have an interest in it, they can always opt for advanced studies.
What is the most difficult branch of bachelors in integrated immunology in Germany?
The most difficult branch of bachelors in integrated immunology in Germany is studying genetics. The subject studies different kinds of DNA and mutant behaviour of the organism.
What is the most popular branch of bachelors in integrated immunology in Germany?
The most popular branch of bachelors in integrated immunology in Germany is medicine. The subject deals with medicines related to the immune system.
What is the highest paying job after completing bachelors in integrated immunology in Germany?
The highest paying job after completing bachelors in integrated immunology in Germany is a biotech scientist. The salary of a biotech scientist costs up to 60,000 EUR monthly.
Can I complete bachelors in integrated immunology in Germany in one year?
No, you cannot complete bachelors in integrated immunology in Germany in one year, but you can have an additional MSc course which is for 12 months for any specialisation. You can also opt for diplomas and internships after your bachelors.
Get free 1-on-1 counselling with our experts